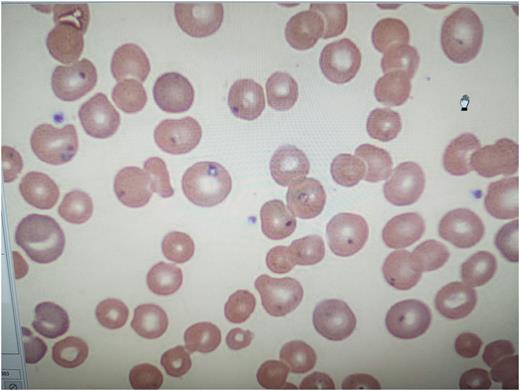
Figure 1

Abstract
Babesia is an obligate intra-erythrocytic parasite transmitted by a tick called Ixodes scapularis . They invade erythrocytes and can present in various hematologic manifestations that can range from mild anemia to severe pancytopenia, splenic rupture, disseminated intravascular coagulation(DIC) or even hemophagocytic lymphohistocytosis1. They are typically self limiting in immunocompetent hosts, however management in splenectomized patients is complex and requires multidisciplinary care.
We present the case of a 60 year old homeless male with a history of splenectomy secondary to a motor vehicle accident 6 years ago who presented to us with severe sepsis. On arrival his systolic blood pressure was in low 90s, tachycardic, tachypneic and saturating 93% on room air. Initial labs were significant for hyponatremia (125), hyperkalemia (5.6), acute renal failure (creatinine 2.18, baseline 0.8-1 and GFR 32, baseline 96-98), hyperuricemia(12.5), hyperphosphatemia(5) with congruent hypocalcemia(7.3).On blood counts hemoglobin(hb) was noted at 9.2 with baseline of 15 with appropriate reticulocytosis, leukocytosis(17.4) with monocytosis(26, normal is less than 11). Other labs include lactate dehydrogenase(LDH) which was elevated five times the normal limit(852) and serum haptoglobin was less than 8 (normal:11-44). He was appropriately fluid resuscitated and started on vancomycin and cefepime by emergency department. Overnight, a critical lab result was received, peripheral smear(pic 1) was showing intraerythrocytic parasites. By next morning, hematology confirmed the presence of Maltese cross on peripheral smear and parasite burden was determined at 20%. We subsequently transitioned the patient to atovaquone 750mg twice daily and IV azithromycin 500 mg daily. Doxycycline 100mg BID was later added by Infectious diseases(ID)to the regimen to empirically cover Lyme disease as both babesia and borrelia share the same tick vector. By day 2 of hospitalization patient was producing less than 0.5ml/kg/hour of urine output with decrease in GFR to 16 and concomitant rise in creatinine to 3.86, hb dropped to 7.8 with with notable rise in LDH(1080). Hematology opined for an urgent exchange transfusion specifically erythrocytapheresis and IR was consulted for a peripherally inserted central catheter insertion for the same. Post exchange transfusion, patient was noted to have improving kidney functions with decrease in parasite burden on serial peripheral smears. His hb remained stable around 10 and GFR improved to 63, at which point he was deemed stable for discharge. ID stepped down therapy to oral azithromycin 500mg daily and atovaquone 750 mg BID and doxycycline for total duration of two weeks at discharge.
The indications of exchange transfusion in severe babesiosis are not well established. Erythrocytapheresis is typically considered in patients with severe hemolysis (hb less than 10), parasitemia greater than 10% or organ failure. However we did not find any prospective randomized studies to support this approach. The data to support erythrocytapheresis versus whole blood or plasma exchange is limited at best in immunocompetent patients2,3,4,5 .Though it should be noted that a prompt reduction in parasitemia markedly improves mortality in immunocompromised patient such as ours especially when used adjunctively to antimicrobial therapy 6.
References
1.Hematologic manifestations of babesiosis. Tamer Akel and Neville Mobarakai,2017 Feb 15. doi: 10.1186/s12941-017-0179-z
2. Parasite burden and red blood cell exchange transfusion for babesiosis.O'Bryan J, Gokhale A, Hendrickson JE, Krause PJ , J Clin Apher. 2021;36(1):127. Epub 2020 Nov 12
3. Severe babesiosis in Long Island: review of 34 cases and their complications.Hatcher JC, Greenberg PD, Antique J, Jimenez-Lucho VE, Clin Infect Dis. 2001;32(8):1117.
4. Red cell exchange transfusion for babesiosis in Rhode Island.Spaete J, Patrozou E, Rich JD, Sweeney JD , J Clin Apher. 2009;24(3):97-105.
5. Adjunctive treatment of clinically severe babesiosis with red blood cell exchange: a case series of nineteen patients.Nixon CP, Park S, Nixon CE, Reece RM, Sweeney JD,Transfusion. 2019;59(8):2629. Epub 2019 May 30.
Disclosures
No relevant conflicts of interest to declare.
Author notes
Asterisk with author names denotes non-ASH members.
This feature is available to Subscribers Only
Sign In or Create an Account Close Modal